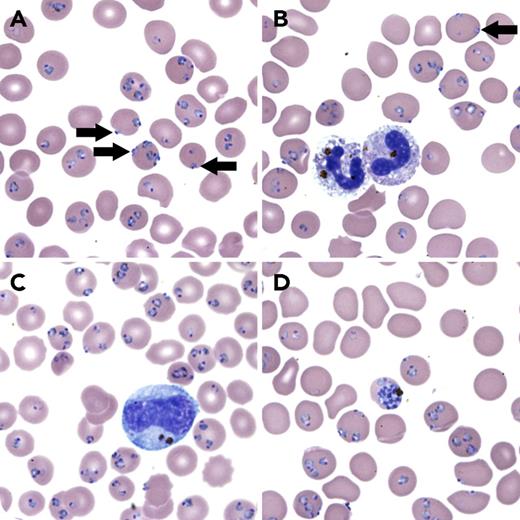
A 27-year-old man developed high fever after returning from sub-Saharan Africa. Trying to overcome this febrile illness during his annual leave (winter season), he had medical home visits, but the fever was repeatedly misdiagnosed as a flulike illness and treated with paracetamol (acetaminophen) only. He eventually collapsed and was brought to hospital with a reduced level of consciousness. The peripheral blood smear confirmed Plasmodium falciparum malaria based on typical morphological changes. Infected red blood cells (RBCs) were normal in size and contained young ring-forms of the same maturation stage, showing occasional accollé/appliqué forms (panel A, arrows; Leishman stain, original magnification ×1000). Contrary to the other species, P falciparum infects RBCs of all ages, which explains the severe hyperparasitemia (44.6%) observed in this case (threshold for severe malaria: >5%). The high number of hemozoin-containing polymorphonuclear leukocytes (25%) (panel B; Leishman stain, original magnification ×1000) was another laboratory indicator of severity (threshold: >5%). Pigmented monocytes were also present (panel C; Leishman stain, original magnification ×1000). Mature pigmented parasites (panel D; Leishman stain, original magnification ×1000) are also a criterion for severity (threshold: >20% of parasites). Unusual is the marked multiparasitism (22%, 1 parasite/RBC; 12%, 2 parasites/RBC; 7%, 3 parasites/RBC; 3.5%, 4 or more parasites/RBC). Theoretically, 80% of all RBCs could have been infected by a single parasite each. / Always consider malaria after a patient has returned from an area where malaria is endemic.

A 27-year-old man developed high fever after returning from sub-Saharan Africa. Trying to overcome this febrile illness during his annual leave (winter season), he had medical home visits, but the fever was repeatedly misdiagnosed as a flulike illness and treated with paracetamol (acetaminophen) only. He eventually collapsed and was brought to hospital with a reduced level of consciousness. The peripheral blood smear confirmed Plasmodium falciparum malaria based on typical morphological changes. Infected red blood cells (RBCs) were normal in size and contained young ring-forms of the same maturation stage, showing occasional accollé/appliqué forms (panel A, arrows; Leishman stain, original magnification ×1000). Contrary to the other species, P falciparum infects RBCs of all ages, which explains the severe hyperparasitemia (44.6%) observed in this case (threshold for severe malaria: >5%). The high number of hemozoin-containing polymorphonuclear leukocytes (25%) (panel B; Leishman stain, original magnification ×1000) was another laboratory indicator of severity (threshold: >5%). Pigmented monocytes were also present (panel C; Leishman stain, original magnification ×1000). Mature pigmented parasites (panel D; Leishman stain, original magnification ×1000) are also a criterion for severity (threshold: >20% of parasites). Unusual is the marked multiparasitism (22%, 1 parasite/RBC; 12%, 2 parasites/RBC; 7%, 3 parasites/RBC; 3.5%, 4 or more parasites/RBC). Theoretically, 80% of all RBCs could have been infected by a single parasite each.
Always consider malaria after a patient has returned from an area where malaria is endemic.
A 27-year-old man developed high fever after returning from sub-Saharan Africa. Trying to overcome this febrile illness during his annual leave (winter season), he had medical home visits, but the fever was repeatedly misdiagnosed as a flulike illness and treated with paracetamol (acetaminophen) only. He eventually collapsed and was brought to hospital with a reduced level of consciousness. The peripheral blood smear confirmed Plasmodium falciparum malaria based on typical morphological changes. Infected red blood cells (RBCs) were normal in size and contained young ring-forms of the same maturation stage, showing occasional accollé/appliqué forms (panel A, arrows; Leishman stain, original magnification ×1000). Contrary to the other species, P falciparum infects RBCs of all ages, which explains the severe hyperparasitemia (44.6%) observed in this case (threshold for severe malaria: >5%). The high number of hemozoin-containing polymorphonuclear leukocytes (25%) (panel B; Leishman stain, original magnification ×1000) was another laboratory indicator of severity (threshold: >5%). Pigmented monocytes were also present (panel C; Leishman stain, original magnification ×1000). Mature pigmented parasites (panel D; Leishman stain, original magnification ×1000) are also a criterion for severity (threshold: >20% of parasites). Unusual is the marked multiparasitism (22%, 1 parasite/RBC; 12%, 2 parasites/RBC; 7%, 3 parasites/RBC; 3.5%, 4 or more parasites/RBC). Theoretically, 80% of all RBCs could have been infected by a single parasite each.
Always consider malaria after a patient has returned from an area where malaria is endemic.
For additional images, visit the ASH Image Bank, a reference and teaching tool that is continually updated with new atlas and case study images. For more information, visit http://imagebank.hematology.org.
This feature is available to Subscribers Only
Sign In or Create an Account Close Modal